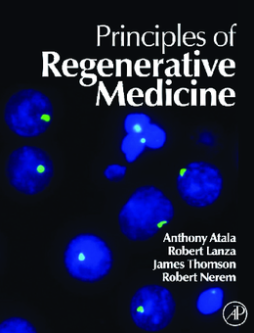

BOOK
Principles of Regenerative Medicine
Anthony Atala | Robert Lanza | Robert Nerem | James A. Thomson
(2011)
Additional Information
Book Details
Abstract
Virtually any disease that results from malfunctioning, damaged, or failing tissues may be potentially cured through regenerative medicine therapies, by either regenerating the damaged tissues in vivo, or by growing the tissues and organs in vitro and implanting them into the patient. Principles of Regenerative Medicine discusses the latest advances in technology and medicine for replacing tissues and organs damaged by disease and of developing therapies for previously untreatable conditions, such as diabetes, heart disease, liver disease, and renal failure.
* Key for all researchers and instituions in Stem Cell Biology, Bioengineering, and Developmental Biology
* The first of its kind to offer an advanced understanding of the latest technologies in regenerative medicine
* New discoveries from leading researchers on restoration of diseased tissues and organs